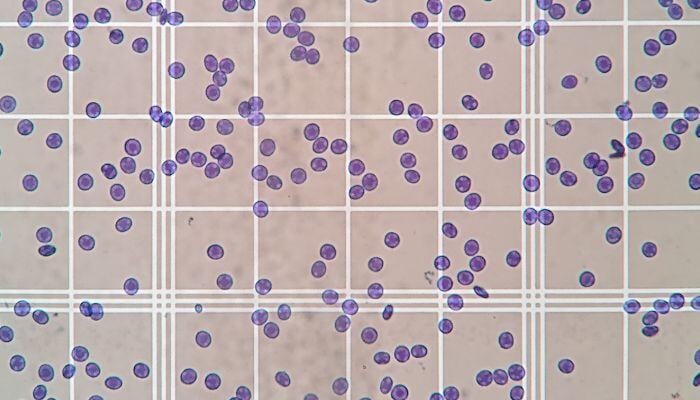

Cerebrospinal Fluid Analysis
We mind what matters. Specialized cerebrospinal fluid analysis to guide your neurologic discoveries.
Tailored CSF analysis, backed by expertise in neurological disease
IDEXX BioAnalytics offers comprehensive cerebrospinal fluid (CSF) analysis services to support neurological research and diagnostics. Utilizing advanced techniques, we analyze the cellular and biochemical components of CSF to detect biomarkers and assess the presence of neurological diseases. Our team of experienced scientists ensures precise and reliable results, providing detailed insights into the central nervous system's health. With rapid turnaround times and a client-centric approach, we aim to provide you with actionable data for informed decision-making.
Our approach to cerebrospinal fluid analysis
Advanced Analytical Techniques
IDEXX BioAnalytics employs state-of-the-art technologies to analyze CSF, ensuring precise and reliable results.
Expert Interpretation
A team of experienced scientists and pathologists provides expert interpretation of the results, helping to elucidate the pathogenesis of diseases.
Rapid Turnaround Times
IDEXX BioAnalytics is known for its fast turnaround times, delivering timely reports that are critical for informed decision-making in research.
Client-Centric Approach
The company works closely with clients to tailor the analysis to their specific research needs, ensuring that the data provided is actionable and relevant.
Fast, accurate, and reliable results from the team you know and trust.
Connect with IDEXX BioAnalytics today.